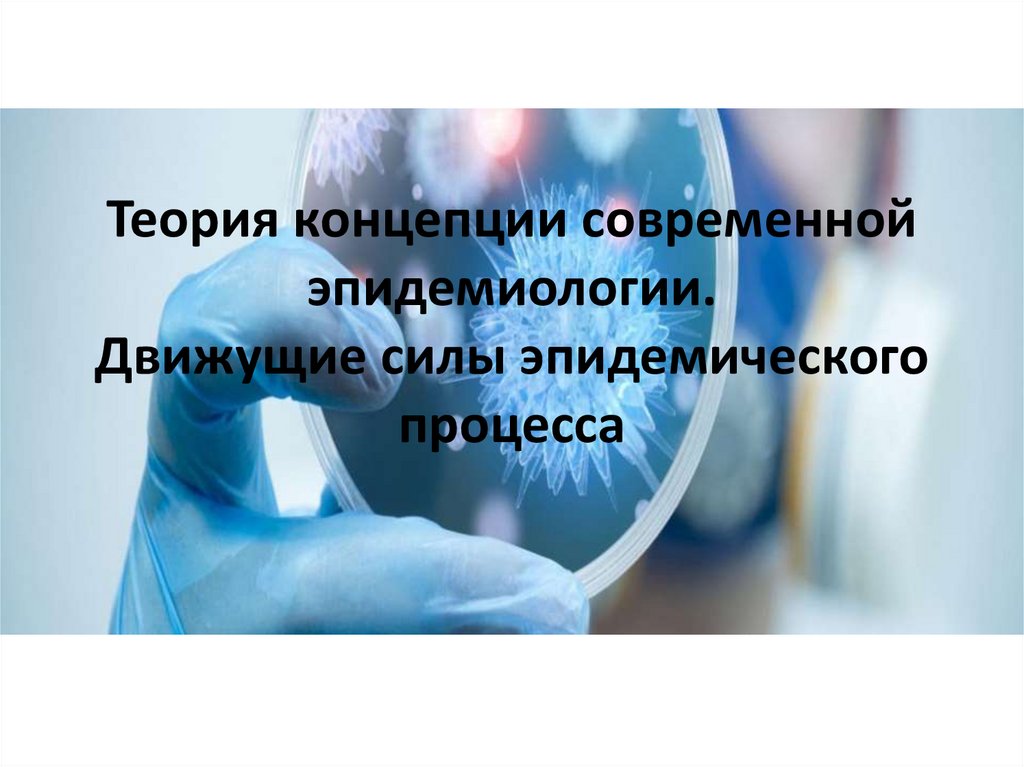

Similar presentations:
Теория концепции современной эпидемиологии. Движущие силы эпидемического процесса
1.
Теория концепции современнойэпидемиологии.
Движущие силы эпидемического
процесса
2.
Среди других важнейшихтеоретических обобщений
ХХ века следует также назвать:
• Теория природной очаговости Е.Н.
Павловского;
• Учение о сапронозах В.И. Терских;
• Теория (концепция) саморегуляции
паразитарных систем В.Д. Белякова;
• Теория соответствия и этиологической
избирательности основных путей передачи
шигеллезов В.И. Покровского, Ю.П.
Солодовникова;
• Социально-экологическая концепция Б.Л.
Черкасского.
3.
1. Учение о механизме передачиЛ.В. Громашевского.
• Согласно Л.В. Громашевского - механизм передачи возбудителя
обеспечивает длительное существование паразитов (возбудителя) при
антропонозных инфекциях – это эпидемический процесс и при зоонозных
заболеваниях – эпизоотический процесс.
• Очень важным как в теоретическом плане, так и для
противоэпидемической практики является один из основных законов
передачи возбудителя, который гласит о непременном соответствии
механизма передачи основной локализации возбудителя в организме
хозяина. Действительно многочисленные эмпирические и научные факты
свидетельствуют, что наиболее выражены в живой природе пищевые
связи т.е. возбудители инфекционных заболеваний попадая в организм
хозяина в своем большинстве имеют выраженный тропизм к
определенным органам и тканям человека: возбудители гриппа к
покровному эпителию верхних дыхательных путей; шигеллы дизентерии
только к слизистой оболочке сигмовидного отдела толстого кишечника;
возбудитель гонореи только к эпителию мочеполовой системы и такой
перечень можно иллюстрировать на довольно значительном материале.
4.
Механизм передачи формируется путейпередачи, которые в свою очередь состоят
из факторов передачи.
• Таким образом Л.В. Громашевский, обобщив
накопленный обширный материал по инфекционной
патологии, разработал учение о механизме передачи
- как о эволюционно выработанном способе,
обеспечивающем паразиту смену индивидуальных
организмов специфического хозяина и поддержание
его как биологического вида в природе длительное
время. Исходя из этого определения на основе
анализа
всего
разнообразия
антропонозных
инфекционных заболеваний им были выделены
четыре механизма передачи: аэрозольный, фекально
- оральный, трансмиссивный и контактный.
5.
В развитие своего учения Л.В. Громашевскимсформулирована трехфакторная концепция
развития эпидемического процесса обобщенная
формулировка, которой гласит: эпидемический
процесс возникает и поддерживается при
сочетанном действии трёх непосредственных
движущих его сил, или агентов которыми
являются:
• наличие источника инфекции;
• осуществление механизма передачи;
• восприимчивость населения к данной
инфекции.
6.
Учение Л.В Громашевского позволило ввести впрактику прогрессивную для своего времени
классификацию инфекционных болезней и обосновать
систему противоэпидемических мероприятий, которая
используется и по настоящее время.
• В своих работах Л.В. Громашевский ЭП пре6дставлен как
однолинейный процесс неизменно вирулентного
возбудителя, что в свою очередь не явления
популяционной изменчивости возбудителей болезней во
время эпидемий и других ситуациях, которое в свою
очередь обуславливало накопление микроорганизмов с
различной степенью вирулентности и не давало ясного
ответа на вопрос каким образом возбудители
высокоманифестных инфекций длительное время
эволюционно сохраняются во внешней среде.
7.
2. Учение о природной очаговостиЕ.Н. Павловского.
• Дальнейшая разработка вопросов инфекционной
патологии позволило сформулировать положение о
том, что на возникновение и развитие эпидемического
процесса (главным образом на механизм передачи
инфекции) при всех инфекционных болезнях природноклиматические условия.
• В 1938 году академик Павловский Е.Н. впервые
выступил с изложением вопросов природной
очаговости ряда инфекционных болезней человека. В
последующие годы в многочисленных работах Е.Н.
Павловского и его учеников по этиологии и
эпидемиологии сезонных энцефалитов, клещевых
риккетсиозов,
лейшманиозов,
туляремии
было
разработано стройное учение о природной очаговости
трансмиссивных зоонозных болезней.
8.
• Природноочаговыеинфекции
это
инфекционные
болезни,
существование
возбудителей которых, поддерживается за счет
циркуляции их в природных очагах. К этим
инфекциям относятся не только зоонозы, а
также сапронозы, резервуаром которых
являются абиотические элементы окружающей
среды.
Природная очаговость установлена для многих
инфекционных заболеваний: чумы, туляремии,
клещевого и японского энцефалита, клещевых
спирохетозов, клещевых риккетсиозов, кожного
лейшманиоза, геморрагических вирусных
лихорадок и др.
9.
Характерными чертами этойгруппы болезней являются:
то, что они имеют природный резервуар возбудителей среди диких животных
(преимущественно грызунов) и птиц, в среде которых постоянно существуют
эпизоотии. Распространение болезней происходит при посредстве кровососущих
членистоногих. Так, клещи, зараженные от больных животных, нападают на
здоровых и передают им инфекцию;
для данной группы заболеваний обязательным условием является сезонность
заболевания, что обусловлено биологией животных - хранителей инфекции в
природе или переносчиков. Так например, заражение чумой от сусликов возможно
лишь в период их активности, но не вовремя зимней спячки. В периоде активности
эпизоотия чумы среди сусликов развивается с особой силой во время расселения
молодняка. Наибольшая заболеваемость людей клещевым энцефалитом
наблюдается в мае - августе - в период наибольшей активности переносчиков клещей;
природноочаговые заболевания связаны с определенной территорией. Заражение
происходит там, где переносчики нападают на человека. Существование
переносчика свойственно только в определенном биотопе, т.е. географическом
ландшафте и отсюда возможность возникновения заболеваний людей связана с
определенными географическими ландшафтами. В одних случаях - широтное
распространение заболеваний, в других « пятнистое » распространение очагов на
значительных территориях. Это понятие рассматривается в специализированном
разделе эпидемиологии - ландшафтной эпидемиологии.
10.
• Суть теории природной очаговостиинфекционных болезней состоит в том, что
она объясняет развитие эпидемий болезней
попаданием в организм людей возбудителей,
существующих в природе за счет циркуляции
среди диких животных.
• Полипатогенность этих возбудителей
объясняет заболеваемость людей, попавших в
среду природной циркуляции возбудителя.
Ареал же природных очагов определяется
ареалом животных естественных хозяев
возбудителя – паразита, а при трансмиссивных
инфекциях и ареалом переносчика.
11.
• По определению Е.Н. Павловского, природная очаговостьтрансмиссивных болезней – это явление, когда возбудитель, его
специфический переносчик и животное (резервуар возбудителя)
в течении смены своих поколений существуют в природных
условиях в составе различных биоценозов (биоценоз –
совокупность популяции видов, населяющих определенную
территорию) независимо от человека неограниченно долгое
время, как в ходе уже своей уже прошедшей эволюции, так и в
настоящий период. Животное, восприимчивое к болезни, её
возбудитель и переносчик являются сочленами биоценоза,
связанного с определенным биотопом. Эти биоценотические
взаимоотношения сложились независимо от человека в процессе
эволюции организмов в определенных условиях среды.
• Е.Н. Павловский ввел понятие природный очаг – это
территория, на которой существуют условия для постоянной
циркуляции возбудителя зоонозов диких животных
неопределенно долгое время.
12.
• В настоящее время наблюдается выраженнаятенденция распространения учения о природной
очаговости на все инфекционные болезни
человека с внечеловеческим резервуаром
возбудителя.
• Е.Н. Павловский ввел в теорию природной
очаговости понятие антропургических – человеком
сделанных очагов.
• Учение о природной очаговости явилось
основанием для изучения и выработки мер
профилактики зоонозов, распространенных на
территории нашей страны и за её пределами.
13.
3. Учение о саморегуляцииэпидемического процесса В.Д.
Белякова.
• Теория саморегуляции паразитарных систем объясняет
волнообразность проявлений эпидемического процесса,
характерную практически для всех инфекционных
заболеваний,
связанную
с
гетерогенностью
и
динамической изменчивостью ряда основных свойств
взаимодействующих популяций паразита и хозяина,
благодаря чему обеспечивается приведение их в
соответствие с изменяющимися условиями их обитания
(жизнедеятельности) и сохранение самой паразитарной
системы. Гомогенность, однородность особей популяции
возбудителя или хозяина неминуемо привела бы
паразитарную систему к разрушению. Материалом для
отбора, селекции (приспособления) в любом временном
интервале является неоднородность состава популяции.
14.
Колебания интенсивности эпидемическогопроцесса в пространстве и во времени
соответствует 4 фазам его развития:
• резервации;
• эпидемического становления возбудителя
инфекции (предэпидемическую);
• эпидемическую;
• резервационного становления возбудителя
инфекции (предрезервационную),
переходящая затем в первую фазу.
15.
Основные положения теории саморегуляцииэпидемического процесса следующие:
1. Взаимодействующие популяции паразита – возбудителя и хозяина
гетерогенны и динамически изменчивы. Гетерогенность популяций состоит в
том, что они состоят из особей с генотипическими и фенотипическими
различиями.
2. Основными варьирующими признаками популяции паразита является
вирулентность, антигенность, чувствительность к воздействию факторов
внешней среды, антибиотикам и бактериофагам и др. Смена состава
популяции возбудителя по указанным признакам представляет собой
проявление внутренних закономерностей развития эпидемического
процесса, а не результат воздействия факторов внешней социальной и
природной среды. Движущей силой изменчивости вирулентности
популяции возбудителя является то, что в организме восприимчивых лиц
накапливаются из гетерогенной популяции возбудителя высоковирулентные
штаммы, а в организме иммунных – маловирулентные. Смена антигенных
вариантов возбудителя объясняется « иммунологическим прессом ».
Антибиотико- резистентные штаммы накапливаются в условиях применения
антибиотиков и т.д.
16.
3. Популяции хозяина гетерогенны по генетически обусловленнойстепени восприимчивости к паразиту, в результате чего при одном
и том же риске заражения одни лица заболевают, другие нет, а
заболевшие переносят различные по степени тяжести
клинические формы заболевания. Популяции хозяина гетерогены
также и по способности вырабатывать и сохранять иммунитет, что
находит отражение в риске повторных заболеваний у отдельных
людей. Динамическая изменчивость соотношения людей в
коллективах по признаку восприимчивости определяется
возрастными и временными изменениями специфической и
неспецифической восприимчивости, миграциями и некоторыми
стрессовыми воздействиями, снижающими резистентность
организма.
4. Саморегулирующая смена фаз резервации возбудителя и его
эпидемического распространения объясняется взаимодействием
динамически изменяющихся популяций паразита и хозяина в ходе
эпидемического процесса. Существование возбудителя в фазе
резервации обеспечивается за счет различных форм носительства
в организме людей со своеобразием иммунологического
гомеостаза.
17.
5. Формирование эпидемического штамма начинается придостижении определенного порога восприимчивых лиц в цепи
циркуляции возбудителя.
6. Переход к фазе резервации наступает при достижении
определенного порога иммунных лиц в цепи циркуляции
возбудителя.
7. Качественные и количественные изменения в развитиии
эпидемического процесса являются результатом саморегуляции
эпидемического процесса под воздействием как меняющихся
социальных и природных условий, внутренних механизмов
функционирования системы.
8. Механизм саморегуляции эпидемического процесса при
отдельных нозологических формах и диапазон необходимых и
достаточных природных и социальных условий его развития
определяют направление его профилактики.
18.
Теория саморегуляции эпидемическогопроцесса применима к тем инфекциям,
механизм передачи которых формирует
иммунитет, т.е. обеспечивает постоянное
массовое распространение возбудителя.
19.
Теория саморегуляции эпидемическогопроцесса открыла новые подходы к:
• группировке противоэпидемических мероприятий соответственно фазам развития эпидемического
процесса;
• создала предпосылки к развитию раздела
эпидемиологии - эпидемиологическая диагностика;
• обосновала систему оценки качества и
эффективности противоэпидемических
мероприятий, как обязательного компонента в
управленческой деятельности в системе
противоэпидемического обслуживания и
дальнейшего развития эпидемиологического
надзора.
20.
4. Социально – экологического концепцияэпидемического процесса Б.Л.Черкасского и
теория соответствия В.И. Покровского.
• Системные концепции организации, функционирования и
развития живого были успешно использованы при
разработке теоретических подходов к проблеме
происхождения
жизни,
принципиальной
схемы
эволюционного процесса, при системной трактовке
функционирования организмов человека и животных и
при разработке проблемы генотипа.
• Социально
экологическая
концепция
Б.Л.
Черкасскогоконстатирует, что социально – экосистемный
уровень
представляет
собой
взаимодействие
эпидемиологической экосистемы с человеческим
обществом.
21.
• Эпидемиологическая экосистема – это паразитарнаясистема эпидемического процесса, связанная с
окружающей ее природной средой обитания,
механизмом передачи возбудителя, и является
обязательным
и
необходимым
условием
возникновения эпидемического процесса.
• Другое
обязательное
условие
–
наличие
соответствующей социальной среды. Наличие этих
двух условий является предпосылкой возникновения
и развития эпидемического процесса, т.е. при
реализации взаимодействия эпидемиологической
экосистемы с социальной средой. Например,
присутствие
природноочаговой
паразитарной
системы
и
населения
служит
условием
(предпосылкой) для возникновения эпидемического
процесса.
22.
В соответствии с территориальной дифференциациейобщества эпидемиологическую социальную экосистему
можно дифференцировать по « вертикали » на локальную,
региональную и глобальную.
Эпидемический процесс на уровне локальной соцэкосистемы ограничен
коллективом – группой лиц, связанной между собой в течении определенного
периода времени в хозяйственном, профессиональном, бытовом или ином
отношении (детские семейные коллективы, коллективы предприятий, воинские
части), т.е. находящиеся в сходных условиях взаимодействия с популяцией
возбудителя (это понятие аналогично с понятием «эпидемический очаг» – место
заражения и пребывания источника возбудителя инфекции вместе с контактными и
окружающей обстановкой, в пределах которой при конкретной инфекции возможно
возникновение вторичных одноименных заболеваний).
На уровне региональной соц. экосистемы эпидемический процесс ограничен
населением данной административной территории (город, район, область,
республика). Она состоит из локальных соцэкосистем (это тоже, что и « эпидемия »
при интенсификации эпидемического процесса).
Эпидемический процесс на уровне глобальной соцэкосистемы состоит из
региональных эпидемиологических соцэкосистем, взаимодействующих с
планетарной средой обитания современного мирового сообщества – « пандемия ».
23.
Социально – экологическая концепцияотражает взаимосвязь эпидемического
процесса с многообразными природными и
социальными условиями жизни
человеческого общества. Системный подход
открывает возможность цельного
восприятия как эпидемического процесса,
так и системы целенаправленной борьбы и
профилактики инфекционных заболеваний.
24.
Исследование эпидемического процесса, каксистемы открывает следующие возможности:
рассматривать эпидемический процесс как один из типов общих систем и,
следовательно, использовать при его анализе общие законы, открытые
системологией;
изучать генетические, молекулярные, микробиологические, иммунологические,
клинические, популяционные, экологические, и социальные аспекты
эпидемиологии в рамках одной системы;
концентрировать внимание исследователей на внутренней структуре
эпидемического процесса, перенеся акценты на функциональное взаимодействие
его структурных частей как причину возникновения, развития и прекращения
эпидемического процесса;
моделировать структуру эпидемического процесса при отдельных нозологических
формах в целях прогнозирование его динами в каждых данных условиях;
корректировать систему массовых профилактических в соответствии с прогнозом
динамики эпидемического процесса.

medicine
medicine








